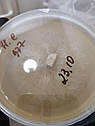
Чиста культура гриба на чашці Петрі, фото 3
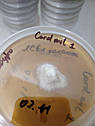
Чиста культура гриба на чашці Петрі, фото 5

1 000 ₴
Пропонуємо до продажу маточний міцелій (чисті культури) їстівних та лікарських видів грибів.
Культури вирощені стерильно на агаризованих поживних середовищах у чашках Петрі. Наявні в
пропозиції штами грибів перевірені на плодоношення на власному виробницві. В процесі
підготовки замовлення контролюється чистота міцелію від стороньої мікрофлори та активність
його росту. Виготовлення та збереження згідно технологічних умов. За потреби надається
сертифікат відповідності.
Набір містить 2 чашки Петрі з міцелієм обраного виду гриба, упакованих асептично (стерильно)
в захистий пекет з фільтром.
Всі фотографії на сайті зроблені на нашому виробництві. В колекції підтримується близько 300
штамів грибів зі всього світу. За наявністю конкретного виду звертайтесь до менеджера.
Види грибів:
Agaricus bisporus
Auricularia auricula-judae
Cordyceps militaris
Cordyceps sinensis
Cyclocybe aegerita
Flammulina velutipes
Grifola frondosa
Ganoderma lucidum
Hericium erinaceus
Hypsizygus marmoreus
Hypsizygus tessellatus
Hymenopellis raphanipes
Lentinula edodes
Laetiporus sulphureus
Morchella esculenta
Pleurotus ostreatus
Pleurotus citrinopileatus
Pleurotus djamor
Pleurotus eryngii
Pleurotus pulmonaris
Pleurotus salmon
Pholiota aurivella
Sparassis crispa
Trametes versicolor
Xerula furfuraceae
| Основні | |
|---|---|
| Тип продукції | Міцелій грибів |
| Країна виробник | Україна |